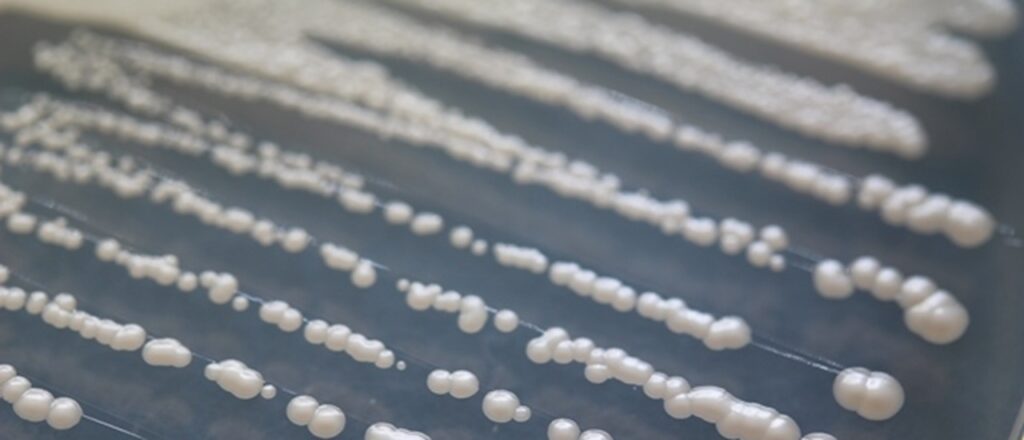

Investigadores de la Universidad de la República, de Montevideo, Uruguay estudiaron las cualidades de las levaduras del género Hanseniaspora y la aplicación de algunas cepas pertenecientes a este género en la cofermentación con Saccharomyces cerevisiae. El estudio demuestra una contribución positiva a la vinificación, obteniendo sabores más intensos, vinos complejos y con cuerpo, en comparación con los vinos producidos mediante el uso de Saccharomyses cerevisiae solo. Además de mejorar el perfil aromático, tiene la capacidad de disminuir el contenido alcohólico, modular la producción de ácidos, aumentar la cantidad de antocianos y disminuir la turbidez en vinos.
Las levaduras del género Hanseniaspora son las más frecuentemente aisladas en uvas y otras frutas. Es habitual que esta especie aparezca al inicio de las fermentaciones espontáneas y después van siendo desplazadas generalmente por Saccharomyces. Existen 23 especies de Hanseniaspora; de ellas 10 se han encontrado asociadas a uvas y vino, dentro de las cuales hay unas muy poco fermentadoras, definidas como de las frutas, y otras como fermentadoras.
En el grupo de las frutas se encuentran Hanseniaspora valbyensis, Hanseniaspora guilliermondii, Hanseniaspora uvarum, Hanseniaspora opuntiae, Hanseniaspora thailandica, Hanseniaspora meyeri, y Hanseniaspora clermontiae, que presentan una evolución caracterizada como rápida debido a su variabilidad genética muy inestable. En el grupo de las fermentadoras se encuentran Hanseniaspora vineae, Hanseniaspora osmophila, y Hanseniaspora occidentalis, que presentan una evolución lenta en su genoma debido a su mayor estabilidad genética. Estas diferencias genéticas tienen también una representación fenotípica, respecto a la capacidad fermentativa y la producción de aromas.
Durante décadas se consideró este género de levaduras como un grupo de microorganismos no deseados para llevar a cabo la fermentación. Especialmente por ser consideradas causantes de aumentar la acidez volátil, aunque esta característica es dependiente de la cepa, hay especies que han sido habitualmente caracterizadas como productoras de ácido acético, especialmente las del grupo de la fruta. Sin embargo, cabe destacar, como ejemplo, que algunas cepas de Hanseniaspora vineae han mostrado una producción de acidez volátil similar o menor a la observada en Saccharomyces cerevisiae en las mismas condiciones de fermentación.
Por otra parte, la capacidad fermentativa de Hanseniaspora es moderada, por ello lo más habitual es usar cultivos mixtos. Sin embargo, el potencial aromático de algunas cepas de Hanseniaspora está empezando a ser explotado por los enólogos para contribuir a una mayor diversidad aromática en los vinos finales con estrategias de co-inoculación con Saccharomyces en baja proporción (10-20% del inoculo inicial). El uso de cultivos mixtos de Hanseniaspora y Saccharomyces además de mejorar el perfil aromático ofrece diversos beneficios. Entre ellos, la disminución del contenido alcohólico, modular la producción de ácidos y aumentar la cantidad de antocianos. Además, debido a la capacidad proteolítica de algunas cepas, puede disminuir la turbidez en vinos.
La forma en que las levaduras contribuyen a la formación de aromas durante el proceso fermentativo es variada. Por una parte, el uso de los aminoácidos a través de diversas rutas metabólicas para producir alcoholes superiores y sus correspondientes acetatos (Fig. 1), que en Hanseniaspora está desarrollado por el gran número de copias de genes que participan de esta vía.

En Hanseniaspora también se ha identificado la alta producción de bencenoides e isoprenoides en comparación con Saccharomyces, que tienen impacto sensorial en el producto final. Algunos sesquiterpenos se destacan con mayor producción en Hanseniaspora que en Saccharomyces, y entre los monoterpenos se ha detectado una producción interesante de safranal en H. vineae, que estaría en concentraciones superiores a su umbral sensorial. Otros procesos que contribuyen al aroma final del vino es la producción de β-glucosidasa extracelular que permite la liberación de precursores aromáticos ligados a azúcares presentes en las uvas, y la lisis celular que libera compuestos relacionados con los aromas y la textura del vino. En esta revisión profundizaremos en los compuestos derivados de aminoácidos aromáticos, la producción de enzimas glucosidasas y lisis celular.
Producción de ésteres de acetatos y alcoholes superiores a partir de aminoácidos aromáticos
El perfil aromático de los vinos producidos con cultivos mixtos de Hanseniaspora y Saccharomyces varía sensiblemente respecto a los vinos elaborados con cultivos puros de Saccharomyces. Esta modulación debida a la interacción de ambas cepas se puede apreciar en el conjunto de los aromas, pero en la mayoría de las fermentaciones lo que se observa más claramente es un aumento significativo de los ésteres de acetato de los alcoholes superiores. Especialmente aquellos producidos a partir de los alcoholes superiores que derivan de aminoácidos aromáticos (feniletanol, triptofol y tirosol). Esta capacidad de acetilación resulta interesante debido a que los acetatos de ésteres de alcoholes superiores tienen un umbral de percepción sensorial más bajo que los correspondientes alcoholes.
La producción de ésteres a partir de un acetato y un alcohol se lleva a cabo en cuatro reacciones consecutivas (Fig. 2A). En primer lugar, una transaminación de los aminoácidos donde participarían homólogos de los genes BAT1, ARO8 y ARO9 (Fig 2B) de S. cerevisiae.

Las especies del género Hanseniaspora que han sido analizadas no presentan homólogos del gen BAT2 que participaría en la transaminación en S. cerevisiae, pero sí tienen varias copias más de los genes ARO que Saccharomyces. Después, los α-cetoácidos resultantes se descarboxilan por acción de los productos de genes como PDC1 y ARO10, dando lugar a los correspondientes aldehídos. Éstos producen alcoholes superiores mediante alcohol deshidrogenasas como las codificadas por ADH6. Estas tres reacciones corresponden al mecanismo de Ehrlich y culminan con la producción de alcoholes superiores. Finalmente, éstos se pueden transformar en ésteres de acetatos mediante la actividad de acetiltransferasas como las codificadas por alcohol acetil transferasas (AAT) que condensan los alcoholes con el grupo carboxílico de la acetil coenzima A. Se conoce que algunas cepas del género Hanseniaspora tienen gran número de copias de genes candidatos relacionados con la acetilación, lo que podría explicar la alta tasa de acetilación de alcoholes superiores que se detecta en el medio extracelular en fermentaciones llevadas a cabo con especies de este género.
ATF1 y ATF2 sintetizan la producción de ésteres volátiles en S. cerevisiae (Verstrepen et al., 2003). En el caso de H. osmophila y H. vineae, presentan ATF2, pero no ATF1 y H. uvarum no presenta homólogos de ninguna de ellas. Sin embargo, hay algunos aminoácidos conservados en las secuencias con homología a ATF2 y una proteína hipotética (GenBank accession number OEJ85955.1), sin homología con S. cerevisiae que presentan dominio AATasa. Recientemente han sido publicadas las primeras herramientas eficientes para modificar genes en H. uvarum. En estos ensayos se llegó a construir un mutante de H. uvarum sin las dos copias de AATasas que presentó una producción de ésteres de acetato mucho menor que la cepa parental.
Se ha visto que también los productos del gen homólogo a SLI1 podrían realizar este paso en Hanseniaspora vineae. En H. vineae, las copias de los genes SLI1 se localizan en tándem dentro del genoma. Cada una de ellas presenta homología con una AATasa de H. osmophila. Sin embargo, las AATasas de H. uvarum se salen de ese clúster.

H. guillermondii UTAD222 tiene 4 genes que codifican AAT y que se expresan diferencialmente a lo largo de la fermentación. Además, según Seixas et al. 2023, esta expresión está modulada por el balance de carbono-nitrógeno en el medio, resultando que menor proporción de carbono respecto a nitrógeno aumenta la actividad acetil transferasa en el medio, generando más acetatos, concretamente más acetato de isoamilo (aroma frutal, banana) y acetato de β-feniletilo (miel, floral).
En S. cerevisiae hay dos regiones esenciales para los genes ATF. El primero es el motivo WRLICLP, el cual no está estrictamente conservado en microorganismos. El segundo es el motivo catalítico H-X-X-X-D que aparece en AATsas vegetales. Los residuos catalíticos His y Asp se ha visto que son cruciales para la función AATasa y forman parte del sitio activo en estas enzimas.
Actividad β-glucosidasa
La mayor parte de los precursores aromáticos de la uva están ligados a azúcares, por esa razón no son perceptibles a través del olfato. Para poder ser percibidos y formar parte del aroma del vino, los compuestos aromáticos tienen que ser liberados para que sean volátiles. En uvas, dos compuestos volátiles importantes que se encuentran ligados son los alcoholes bencílico y β-feniletílico que, según el proceso de fermentación utilizado, se liberan en menor o mayor proporción (Versini et al. 1999). La actividad enzimática que participa en este proceso de liberación es la β-glucosidasa que rompe enlaces glucosídicos. Esta actividad está presente en las uvas y también en algunos microorganismos, pero se encuentra inhibida por azúcares. La actividad β-glucosidasa se puede dar avanzada la fermentación. Por ello la selección de levaduras que tengan esta actividad puede ser de interés para liberar aromas varietales en el proceso de vinificación.
No es común que las levaduras Saccharomyces tengan esta actividad, sin embargo, las especies del género Hanseniaspora pueden crecer en celobiosa como única fuente de carbono, lo que demuestra que tienen actividad β-gluc. En un estudio de 2011 se vieron diferencias en la intensidad de actividad β-glucosidasa en 3 cepas de H. vineae y 3 cepas de H. uvarum de forma semicuantitativa. Más recientemente, en un estudio realizado con 26 cepas diferentes de H. uvarum se vio que presentaban distintos niveles de actividad β-glucosidasa analizando aromas liberados por esta enzima por cromatografía.
Realizando una comparación in silico de diferentes secuencias de posibles β-glucosidasas en los genomas de Hanseniaspora vemos que se presentan diferencias entre ellas. Atendiendo a la predicción de secuencia de aminoácidos de las distintas actividades β-glucosidasa, es evidente que se pueden relacionar las secuencias de las especies de Hanseniaspora que corresponden al grupo del vino y al grupo de la fruta. Existen tres tipos de β-glucosidasa atendiendo a la clasificación filogenética de sus secuencias (Fig. 3).

Y algunas cepas pueden presentar varias actividades con distinta secuencia en su genoma. Este es el caso de H. osmophila AWRI3579 que tiene tres homólogos de β-glucosidasa, uno parecido a la única encontrada en H. vineae y otros dos diferentes.
Lisis celular
En el caso particular de la especie H. vineae se ha comprobado que varias cepas presentan una detención en el ciclo celular. Esta parada no se observó en otras especies del género como H. uvarum, H. opuntiae o H. osmophila y tampoco en Saccharomyces. H. osmophila, H. opuntiae y H. uvarum, muestran un comportamiento similar a S. cerevisiae. Según lo esperable, hay una gran proporción de células en fase G2/M en las fases de crecimiento rápido o exponencial, pero a medida que llegan a la fase estacionaria, la mayoría de las células se encuentran en un estado de quiescencia en fase G0. H. vineae, por el contrario, detiene su ciclo celular en G2/M en la fase estacionaria.
La explicación parece ser una respuesta a la alta concentración de nitrógeno. Para elucidar esta diferencia en el comportamiento de la especie H. vineae se buscaron genes que pudieran variar entre H. osmophila y H. vineae, ambas pertenecientes al clado de evolución lenta. Se encontraron 38 genes ausentes en H. vineae en comparación con H. osmophila. De entre estos genes, es especialmente interesante ATG5 que codifica una proteína conservada relacionada con la respuesta autofágica y las dianas de la vía citoplasma-vacuola. Este gen también se ha relacionado con la vía de la diana de rapamicina (TOR) y la entrada en estado de quiescencia. Su producto, ATG5p pertenece a la ruta de autofagia en las levaduras donde es parte de un complejo citosólico para formar el autofagosoma.
Esta capacidad de autólisis permite la liberación de compuestos aromáticos en el vino, especialmente nucleótidos y nucleósidos que modifican las propiedades organolépticas del producto. El flavor en vinos envejecidos sobre las lías tiene características diferentes a otros vinos, se caracterizan por poseer más cuerpo y complejidad aromática. En el caso de fermentaciones llevadas a cabo con H. vineae se ha visto que esta característica se halla resaltada respecto a las que solo tienen S. cerevisiae, probablemente porque la primera presenta lisis celular más rápida. Otros compuestos liberados en la lisis celular son los polisacáridos que incrementan la persistencia del aroma y mejoran la sensación en boca (Loira et al. 2018) y también proteínas y ácidos grasos que influyen en la espumosidad para vinos blancos base.
Conclusión
Las levaduras del género Hanseniaspora poseen cualidades muy interesantes debido a la alta producción de compuestos aromáticos distintivos. Con las nuevas herramientas de modificación genética en estas especies será más fácil describir al detalle las rutas biosintéticas para la producción de compuestos aromáticos y su regulación. Esto nos permitirá aprovechar el potencial biotecnológico de este grupo de levaduras para la producción de vinos de gran calidad con cultivos mixtos.
Fuente: ACE Enología. Autores: Maria José Valera, Valentina Martin, Eduardo Boido y Francisco Carrau, del Área Enología y Biotecnología de Fermentaciones del Departamento de Ciencia y Tecnología de Alimentos. Facultad de Química, Universidad de la República. Montevideo, Uruguay.